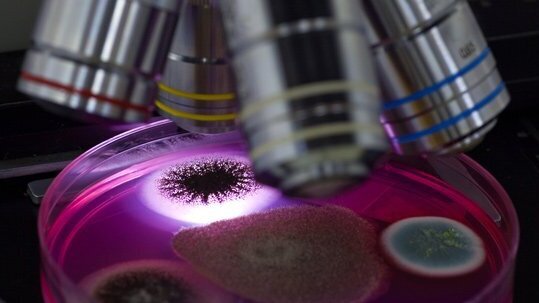
Auf der Suche nach der EHEC-Quelle

ZÜRICH - Erkrankungen durch Shigatoxin-bildende Escherichia coli-Bakterien, wie sie zur Zeit in Norddeutschland auftreten, sind in der Schweiz seit 1999 meldepflichtig. Seither werden sie am Institut für Lebensmittelsicherheit und -hygiene der Universität Zürich umfassend erforscht.
Es gibt in der Schweiz wohl niemanden, der sich mit der Verbreitung von Escherichia coli-Bakterien so gut auskennt wie Roger Stephan, Leiter des Instituts für Lebensmittelsicherheit und -hygiene der Universität Zürich.
Und im Moment hat er besonders viel zu tun. Jeder Gemüseverkäufer in der Schweiz will sicher sein, dass auf seinem Gemüse keine dieser krankmachenden Keime sind. Deshalb wird nun sehr viel getestet. Das Institut der Universität Zürich ist das einzige Labor in der Schweiz, das solche Tests durchführt.
In der Schweiz ist der Erreger, der in Deutschland bis heute für rund 1400 Erkrankungen und 16 Tote verantwortlich ist, bisher nirgends nachgewiesen worden. Die beiden Schweizer, die erkrankt sind, haben sich im Ausland angesteckt.
Verbreitetes Bakterium
Escherichia coli, auch Kolibakterien genannt, kommen natürlicherweise im Darm von Säugetieren vor. Im Darm sind sie nützlich und gehören zur normalen Darmflora. Auch Bakterien können von Viren, sogenannten Prophagen, befallen werden, und irgendwann haben vermutlich solche Viren gift-produzierende Eigenschaften von anderen Organismen übertragen.
Die Stämme mit dieser Eigenschaft nennt man Shigatoxin-bildende Escherichia coli, kurz STEC. Sie sind sehr weit verbreitet. «Wenn alle STEC, die es gibt, hoch gefährlich wären, dann wären wir alle nur noch krank», sagt Stephan. Nur ein Teil dieser STEC verursacht Durchfallerkrankungen und nur ein kleiner Teil schwere Komplikationen.
Die Bakterien werden üblicherweise von Rindern auf Menschen übertragen. Aktuelle Resultate zeigen, dass 75 Prozent der Rinder STEC ausscheiden. Sie werden dabei selber nicht krank. Alle Wiederkäuer sind Quellen für diese Erreger: Rinder, Schafe, Ziegen, Rehe, Hirsche. Im Stall, im Wald, im Streichelzoo. Ein riesiges Reservoir. «Wenn man nur lange genug sucht, findet man sie überall», betont Stephan.
Neuartiger Erreger
Die EHEC, die enterohämorrhagischen Escherichia coli, die für den Ausbruch der Seuche in Deutschland verantwortlichen sind, sind eine Untergruppe der STEC. Es gibt verschiedene Bausteine, die vorhanden sind oder eben fehlen können. «Es handelt sich dabei aber nicht um Mutationen», sagt Experte Stephan. Die Untersuchung von Patientendaten aus zehn Jahren zeigt, dass bei gefährlichen Komplikationen praktisch immer die gleichen zwei Bausteine vorhanden sind.
Neu ist, dass ausgerechnet der Stamm in Deutschland nur einen dieser Bausteine aufweist. Ebenfalls neu ist, dass ein spezielles Antibiotika-Resistenzplasmid vorkommt. Die Antibiotika-Resistenz ist jedoch in diesem Fall problemlos, weil bei dieser Erkrankung sowieso keine Antibiotika gegeben werden, da sie zu vermehrter Toxinproduktion führen.
Gülle als Keimquelle unwahrscheinlich
Bei den Erkrankten in Deutschland handelt es sich vorwiegend um Frauen. Auch das ist neu. Gemeinsames Merkmal der Erkrankten: Sie haben im Vergleich mit einer Kontrollgruppe überdurchschnittlich oft rohe Gurken, Tomaten und Salat gegessen. Deshalb kamen die zuständigen Stellen auch schnell auf die Idee, dass der Erreger im Gemüse zu suchen sein müsse. Es gibt sonst offenbar nichts, was die Fälle verbindet.
Roger Stephan kann sich nicht vorstellen, dass die Keime, wie auch schon behauptet, mit der Gülle auf das Gemüse gekommen sind. Viel wahrscheinlicher sei, dass es belastetes Wasser gewesen ist. STEC können in allen Oberflächengewässern vorkommen. Nach einer längeren Trockenzeit, wenn das Wasser in den Flüssen zurückgeht, kann die Konzentration ansteigen. Und während einer Trockenzeit wird oft mit Flusswasser bewässert.
Heute scheint zumindest klar, dass auf den verdächtigten Gurken aus Spanien zwar STEC gefunden wurden, jedoch nicht der neuartige Erreger. Die Gurken waren also offenbar nicht der Grund für den Ausbruch der Krankheit in Norddeutschland. Die Suche geht also weiter.
Hamburger und Kuheuter
Eine Erkrankung durch Shigatoxin-bildende Escherichia coli-Bakterien, kurz: STEC, wird auch als «Hamburger-Krankheit» bezeichnet. Vom Ausbruch der EHEC-Seuche, einer Untergruppe der STEC, ist die Stadt Hamburg mit aktuell fast 700 Verdachtsfälle zwar am meisten betroffen, doch der Name «Hamburger-Krankheit» kommt aus einer ganz anderen Ecke: Im Jahr 1983 erkrankten in den USA Hunderte von Menschen nach dem Konsum von ungenügend durchgebratenen Hamburgern. Auffallend ist, dass es in der Schweiz in den letzten zehn Jahren keine eigentlichen Ausbrüche mit einer einzigen Quelle gegeben hat. Die Erkrankungen treten jeweils vereinzelt und sporadisch auf. 30 bis 70 Fälle sind es insgesamt jedes Jahr. Meistens trifft es Kinder unter fünf Jahre.
Ein weiteres Risikolebensmittel ist Rohmilch. «Vom lebensmittelhygienischen Standpunkt aus gesehen sind die Euter wirklich am dümmsten Ort», meint Roger Stephan, Leiter des Instituts für Lebensmittelsicherheit und -hygiene der Universität Zürich. Die pasteurisierte Milch im Regal ist unbedenklich, doch die Keime können den Reifungsprozess beim Rohmilchkäse überleben. Zur Zeit läuft ein Versuch, den Prozess der Käseherstellung so zu modifizieren, dass die Erreger verschwinden.
LONDON – Ein wirksamer und sicherer Impfstoff gegen COVID-19 gilt als die entscheidende Waffe im Kampf gegen die Coronavirus-Pandemie. Die London School ...
HALLE (SAALE) - Zielsicher, effizient und ohne viele Nebenwirkungen: Ein neuer Ansatz zur Bekämpfung von Parodontitis könnte womöglich den Einsatz von ...
WASHINGTON, USA – Die Sucht nach dem Bleichen ist eine Erkrankung, von der zunehmend amerikanische Zahnärzte berichten. Die Folgen der ...
Bern – Mitte August verpflichteten sich 21 Schweizer Lebensmittelunternehmen freiwillig, den Zucker in ihren Lebensmitteln und Erfrischungsgetränken ...
Shanghai – Auf dem FDI World Dental Congress 2025 (WDC25) präsentierte die FDI einen neuen Leitfaden zur Interessenvertretung, der effektive Maßnahmen ...
ZÜRICH - Vitamin B12 ist lebenswichtig. Nun ist es Forschenden vom Kinderspital Zürich und von der Universität Zürich mit einem Team aus...
Neuchâtel – Personen, die 2012 einen Bildungsabschluss erlangt und sich danach weitergebildet haben, verdienen zehn Jahre später zwischen 400 und 1300 ...
BASEL – Ein Viertel der Menschheit leidet zu bestimmten Tageszeiten unter sozial unverträglichem Mundgeruch, 6% aller Personen ...
SHEFFIELD - Laut einem britischen Biologen wird die Evolution dem Menschen in ferner Zukunft schnabelartige Kauleisten bescheren, ganz ähnlich wie ...
München – Nach vielen Jahren am Standort Theresienhöhe bezog Henry Schein Dental Deutschland in München am 18. Juli 2025 die neuen Räumlichkeiten im ...
Live-Webinar
Di. 23. Juni 2026
2:00 Uhr (CET) Zurich
Live-Webinar
Di. 23. Juni 2026
19:00 Uhr (CET) Zurich
Live-Webinar
Di. 23. Juni 2026
21:00 Uhr (CET) Zurich
Live-Webinar
Mi. 24. Juni 2026
14:00 Uhr (CET) Zurich
Live-Webinar
Mi. 24. Juni 2026
17:00 Uhr (CET) Zurich
Live-Webinar
Mi. 24. Juni 2026
18:30 Uhr (CET) Zurich
Dr. med. dent. Britta Hahn
Live-Webinar
Do. 25. Juni 2026
20:00 Uhr (CET) Zurich
Dr. Hatem Algraffee, Cat Edney



 Österreich / Österreich
Österreich / Österreich
 Bosnien und Herzegowina / Босна и Херцеговина
Bosnien und Herzegowina / Босна и Херцеговина
 Bulgarien / България
Bulgarien / България
 Kroatien / Hrvatska
Kroatien / Hrvatska
 Tschechien & Slowakei / Česká republika & Slovensko
Tschechien & Slowakei / Česká republika & Slovensko
 Frankreich / France
Frankreich / France
 Deutschland / Deutschland
Deutschland / Deutschland
 Griechenland / ΕΛΛΑΔΑ
Griechenland / ΕΛΛΑΔΑ
 Ungarn / Hungary
Ungarn / Hungary
 Italien / Italia
Italien / Italia
 Niederlande / Nederland
Niederlande / Nederland
 Nordic / Nordic
Nordic / Nordic
 Polen / Polska
Polen / Polska
 Portugal / Portugal
Portugal / Portugal
 Rumänien & Moldawien / România & Moldova
Rumänien & Moldawien / România & Moldova
 Slowenien / Slovenija
Slowenien / Slovenija
 Serbien & Montenegro / Србија и Црна Гора
Serbien & Montenegro / Србија и Црна Гора
 Spanien / España
Spanien / España
 Schweiz / Schweiz
Schweiz / Schweiz
 Türkei / Türkiye
Türkei / Türkiye
 Großbritannien und Irland / UK & Ireland
Großbritannien und Irland / UK & Ireland
 International / International
International / International
 Brasilien / Brasil
Brasilien / Brasil
 Kanada / Canada
Kanada / Canada
 Lateinamerika / Latinoamérica
Lateinamerika / Latinoamérica
 USA / USA
USA / USA
 China / 中国
China / 中国
 Indien / भारत गणराज्य
Indien / भारत गणराज्य
 Pakistan / Pākistān
Pakistan / Pākistān
 Vietnam / Việt Nam
Vietnam / Việt Nam
 ASEAN / ASEAN
ASEAN / ASEAN
 Israel / מְדִינַת יִשְׂרָאֵל
Israel / מְדִינַת יִשְׂרָאֵל
 Algerien, Marokko und Tunesien / الجزائر والمغرب وتونس
Algerien, Marokko und Tunesien / الجزائر والمغرب وتونس
 Naher Osten / Middle East
Naher Osten / Middle East

To post a reply please login or register